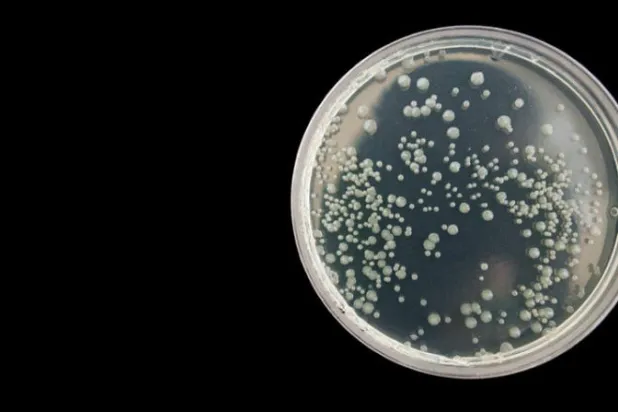
بكتيريا تواجه المضادات الحيوية بـ«النوم»

سويسرا أخبار
سويسرا أخبار
منذ بداية جائحة «كوفيد - 19» حتى مطالع العام الحالي لم يتوقَّف عداد الإصابات الجديدة والوفيات في العالم عن الارتفاع. فأرقام الإصابات والوفيات في أبريل (نيسان)، من العام الماضي، زادت بنسبة 23 في المائة عن أرقام مارس (آذار)، بداية انتشار الوباء. وإصابات فصل الصيف كادت تمثل ضعف إصابات الربيع، فيما حطمت أعداد الشتاء كل الأرقام القياسية السابقة. لكن البيانات الأخيرة المتوفرة لدى «منظمة الصحة العالمية» تفيد بأن عدد الإصابات العالمية الجديدة يتراجع للأسبوع السادس على التوالي، فيما يتراجع عدد الوفيات أيضاً منذ مطلع أواخر الشهر الماضي.
تتولى نغوزي أوكونجو - إيويالا مقاليد منظمة التجارة العالمية في الأول من مارس (آذار) المقبل، وتأمل أن تبث روحاً جديدة في منظمة ضعيفة عليها أن تعود إلى تبني هدف تحسين معيشة الناس، وتعزيز وصول البلدان الفقيرة إلى لقاحات (كوفيد - 19). وقالت نغوزي: «أعتقد أن منظمة التجارة العالمية أهم من أن يتم إبطاؤها وشل حركتها وتركها تحتضر... هذا ليس صائبا».
أعلنت المديرة العامة الجديدة لمنظمة التجارة العالمية نغوزي أوكونغو - إيويلا في مقابلة مع وكالة الصحافة الفرنسية أمس (الثلاثاء)، أنّه يجب على المنظمة أن تساعد في تسهيل حصول الدول الفقيرة على اللقاحات المضادّة لفيروس «كورونا». وقالت الخبيرة الاقتصادية النيجيرية: «أعتقد أنّه بإمكان منظمة التجارة العالمية أن تسهم أكثر في حلّ أزمة جائحة (كوفيد - 19) من خلال المساعدة في تسهيل حصول الدول الفقيرة على اللقاحات». وأضافت أنّ من واجب المنظّمة أيضاً أن تساعد في تحقيق هدفها الأول المتمثّل «في تحسين مستويات المعيشة» في الدول الفقيرة. ومن الجدير ذكره أن أوكونغو - إيويلا هي أول شخص أفريقي وأول امرأة تشغل منصب
وصف أحمد المنظري، مدير إقليم شرق المتوسط في «منظمة الصحة العالمية»، الوضع الوبائي الخاص بانتشار جائحة «كوفيد-19» بأنه «لا يزل حرجاً»، رغم «الاستقرار في عدد الحالات بوجه عام».
أدرجت منظمة الصحة العالمية أمس اللقاح المضاد لكوفيد - 19 الذي طورته شركة «أسترازينيكا» بالتعاون مع جامعة أكسفورد، ضمن قائمتها للقاحات الاستخدام الطارئ، ما يوسع نطاق الحصول على هذا اللقاح الرخيص نسبياً لدى الدول النامية. وقال مدير عام المنظمة تيدروس أدهانوم جيبريسوس: «لدينا الآن جميع لوازم التوزيع السريع للقاحات. لكننا لا نزال بحاجة إلى زيادة الإنتاج».
تتهرب البكتيريا المقاومة للمضادات الحيوية من تأثيرات العلاج عن طريق تحطيمه، لكن بعض البكتيريا لديها استراتيجية أخرى للبقاء على قيد الحياة، فهي تتحمل العلاج من خلال الدخول في حالة شبيهة بالنوم تمكنها من تحمل المضادات الحيوية، وبمجرد اكتمال العلاج، تستيقظ البكتيريا وتعيد العدوى، ويمكن أن تؤدي هذه الحالة «المثبطة» إلى التهابات متكررة ويصعب علاجها. ووصفت منظمة الصحة العالمية مقاومة المضادات الحيوية، بأنها الجائحة القادمة التي ستواجه البشرية، واصفة في مؤتمر صحافي في نوفمبر (تشرين الثاني) الماضي، مقاومة البكتريا المتنامية للمضادات الحيوية، بأنها لا تقل خطورة عن جائحة «كوفيد - 19».
أظهرت دراسة قام بها قسم علم الأحياء التطوري والدراسات البيئية بجامعة زيوريخ السويسرية، أن إناث الزرافات البالغة التي تعيش في مجموعات، تتمتع بطول العمر عن الأفراد المعزولين اجتماعياً. وخلال خمس سنوات درس خلالها الفريق البحثي الزرافات في منطقة تارانجير بتنزانيا، وفحص التأثيرات النسبية للتواصل الاجتماعي، والبيئة الطبيعية، والعوامل البشرية على معدلات البقاء، توصلوا لهذه النتيجة التي نشرت أمس في دورية «بروسيدنج أوف ذا رويال سوسيتي». وتعد تشكيلات مجموعة الزرافة ديناميكية وتتغير على مدار اليوم، لكن الإناث البالغات يحتفظن بالعديد من الصداقات المحددة على المدى الطويل، ووجدت الدراسة أن التجمع مع عدد أكب
أكدت مسؤولة رفيعة في منظمة الصحة العالمية، أن المعركة ضد الوباء لم تنته بعد رغم ظهور اللقاح وانخراط عدد من البلدان في التطعيم، منوهة إلى أن اللقاح وسيلة بالغة الأهمية لاحتواء الجائحة، لكنه ليس الوسيلة الوحيدة، مشددة على أنه يتعين مواصلة تطبيق سائر الإجراءات الاحترازية والتدابير الوقائية للصحة العامة. وقالت الدكتورة رنا حجة مديرة إدارة البرامج في منظمة الصحة العالمية لـ«الشرق الأوسط» إن أحد أهم الأمور التي يتم التأكيد عليها هي التوزيع العادل والمنصف للقاحات، وعدم استئثار بعض الدول بها دون غيرها، «بحيث يصل سريعاً للفئات ذات الأولوية في كل بلد دون أن تكون الإمكانات المالية عائقاً».
أحال النائب العام التمييزي في لبنان النتيجة الأولية لطلب مساعدة قضائية مقدم من السلطات السويسرية، في قضية غسل أموال تتعلق بمصرف لبنان المركزي، وفقا الوكالة الوطنية اللبنانية للإعلام. وأضافت الوكالة الرسمية أن القاضي غسان عويدات أرسل، اليوم (الخميس)، المعلومات عبر القنوات الدبلوماسية وطلب في المقابل تزويده بالمستندات الموجودة لدى المحققين السويسريين، بحسب ما نقلت وكالة «رويترز» للأنباء. وأجاب حاكم مصرف لبنان المركزي رياض سلامة، اليوم، عن أسئلة من مدعي عام التمييز اللبناني بناء على طلب من محققين سويسريين ينظرون في مزاعم غسل أموال واختلاس ترتبط بالبنك المركزي. وقال سلامة، في بيان، إنه أبلغ المدعي
أعلنت منظمة الصحة العالمية أنه على الرغم من تزايد عدد الإصابات بالمرض، فإنه من الممكن الوقاية من الإصابة به.
لم تكفّ منظمة الصحة العالمية على مدى الأشهر الماضية عن تحذير الدول الغنيّة من أن حملات التطعيم ضد {كوفيد - 19} لن تكون كافية وحدها للقضاء على الوباء بشكل نهائي ما لم توزّع اللقاحات في الوقت المناسب على جميع البلدان، ما يتيح استئناف النشاط الاقتصادي وإعادة الحياة إلى حركة التجارة والتنقلات الدولية.
حضت مسؤولة في منظمة الصحة العالمية على البدء بالسعي لفهم لغز «كوفيد الطويل الأمد» الذي يعاني منه على ما تفيد البيانات ملايين المصابين بوباء «كوفيد – 19» من دون أن تعرف الأسباب، حسب ما أوردت وكالة الصحافة الفرنسية في تقرير من جنيف أمس. وبعد عام على بدء تفشي الوباء الذي حصد أكثر من 2.1 مليون شخص، يتركز الاهتمام حالياً على حملات التلقيح والنسخ المتحورة عن فيروس كورونا المستجد.
بعد الإنجازات غير المسبوقة التي حققتها البحوث لتطوير وإنتاج اللقاحات ضد (كوفيد - 19)، تواصل الأوساط العلمية معركتها المستميتة لإيجاد علاج ناجع ضد الالتهابات التنفسية الناجمة عن الإصابة بالفيروس، ومنع تفاقمها حتى درجة التسبب بالوفاة.
حذرت منظمة الصحة العالمية من أن الهوة تتسع بين الأغنياء والفقراء بشأن الحصول على اللقاحات، مشيرة إلى أنها لا تزال بحاجة إلى 26 مليار دولار لآليتها الرامية إلى تسريع نشر أدوات مكافحة «كوفيد - 19» في العالم. وقال المدير العام لمنظمة الصحة تيدروس أدهانوم غيبرييسوس، «في وقت نتكلم الآن، تنشر الدول الغنية لقاحات في حين تكتفي الدول الأقل تطوراً بالمشاهدة والانتظار». وأضاف في مؤتمر صحافي أول من أمس (الاثنين): «في كل يوم ينقضي تزداد الهوة بين الأثرياء والفقراء».
تسبب وباء كوفيد-19 في «أضرار بالغة» في قطاع الوظائف مع خسارة ما يعادل 255 مليون وظيفة عام 2020، بحسب ما أعلنت منظمة العمل الدولية الاثنين. وقالت المنظمة التابعة للأمم المتحدة في تقريرها السابع المخصص لآثار الوباء على عالم الأعمال إنه في عام 2020 «تمت خسارة 8,8 في المائة من ساعات العمل في العالم (مقارنة مع الفصل الرابع عام 2019) ما يعادل 255 مليون وظيفة بدوام كامل»، أي خسارة ساعات عمل أكثر بمعدل أربع مرات مقارنة مع فترة الأزمة المالية عام 2009. وأفاد جاي رايدر رئيس منظمة العمل الدولية متحدثا إلى الصحافيين عبر الإنترنت بأن «هذه أشد أزمة في عالم العمل منذ الكساد الكبير في الثلاثينيات». ومنذ ظهور
أدانت محكمة جنائية سويسرية، أمس الجمعة، رجل الأعمال الإسرائيلي بيني شتاينمتز بتهمة الفساد والتزوير وحكمت عليه بالسجن خمس سنوات مع غرامة ضخمة، في حكم تاريخي بإحدى أبرز القضايا المتعلقة بقطاع التعدين في العالم. والحكم الصادر بعد محاكمة استمرت أسبوعين صفعة لشتاينمتز تاجر الألماس الذي وضعه سعيه وراء أكثر مخزونات الحديد الخام ثراء في العالم في قلب معركة أدت إلى بدء تحقيقات ودعاوى قضائية في أنحاء مختلفة من العالم. وقال شتاينمتز، الذي وصف الحكم بأنه «ظلم كبير»، إنه سيستأنف ضده.
أعلنت منظمة الصحة العالمية أمس (الجمعة) أنه من المبكر جداً التوصل إلى أي استنتاجات تتعلق بعمل بعثتها إلى ووهان وما إذا كانت جائحة كوفيد - 19 قد بدأت في الصين، وفقاً لوكالة الصحافة الفرنسية. وكان فريق من خبراء المنظمة وصل إلى ووهان في 14 يناير (كانون الثاني) للتحقيق في منشأ فيروس كورونا، بعد أكثر من عام على ظهور أولى الإصابات في المدينة بوسط الصين. ونقل أفراد البعثة إلى فندق لقضاء حجر صحي. وتترقب الصين تدقيق فريق الخبراء العاملين لدى منظمة الصحة العالمية وما العناصر التي سيضيفونها إلى روايتها المتعلقة بالفيروس، خصوصاً أنها روجت شيئاً فشيئاً لفكرة أن الوباء بدأ خارج حدودها. وقال مايكل رايان، مدي
أبدى 63% من السويسريين تأييدهم مبادرة لحظر «إخفاء» الوجه في الأماكن العامة، حسب أول استطلاع يجري حول الموضوع ونشرته مجموعة «تاميديا» الصحافية، اليوم (الجمعة). ويشير هذا الاستطلاع الذي أُجري في يناير (كانون الثاني) وشمل أكثر من 15 ألف شخص، ونشرته وكالة الأنباء السويسرية، إلى أن 35% من الذين تم استطلاع رأيهم يعارضون النص الذي وصفته وسائل الإعلام السويسرية بأنه «مبادرة حظر النقاب»، فيما لم يتمكن 2% من تحديد موقفهم، حسبما أفادت وكالة الصحافة الفرنسية. وقد أعربت الحكومة عن معارضتها للنص الذي تعدّه «غير ضروري» لأن النساء اللواتي يرتدين النقاب، هن بشكل رئيسي من السياح. من المقرر أن يصوّت السويسريون ف
يرى قادة قطاع الأعمال والحكومات حالياً أن الوفيات الناجمة عن «كوفيد - 19» والتداعيات الاقتصادية للجائحة، تمثلان أكبر تهديد في العالم على المدى القصير، وفق المنتدى الاقتصادي العالمي، حسب وكالة الصحافة الفرنسية. والمنتدى الذي ينظّم تجمعاً سنوياً يضمّ قادة عالم الأعمال والسياسة في منتجع دافوس بجبال الألب السويسرية، يستطلع آراء أعضائه مسبقاً لمعرفة ما الذي يعدّونه أكبر تهديدات على مستوى العالم. ومن غير المستغرب أن يكون وباء فيروس «كورونا» في مقدمة المخاطر في المدى القريب، علماً بأن التغير المناخي لا يزال بين أكبر المخاوف على المدى البعيد. وجاء في تقرير المخاطر العالمية الصادر عن المنتدى أن «التكلف
قالت وزيرة العدل اللبنانية اليوم (الثلاثاء) إنها تسلمت طلب تعاون قضائي من السلطات القضائية في سويسرا يتعلق بتقديم مساعدة قضائية حول ملف تحويلات مالية تخص حاكم مصرف لبنان المركزي رياض سلامة. وقال سلامة إنه سينظر في التقرير، وأشار لـوكالة «رويترز» أنه «ليس لديه أي معلومات وسينظر في الأمر». وأضح سلامة اليوم أن «كل الادعاءات عن تحاويل مالية مزعومة قام بها إلى الخارج سواء باسمه أو باسم شقيقه أو باسم معاونته إنما هي فبركات وأخبار كاذبة لا أساس لها». وأكد مسؤول حكومي أن السلطات السويسرية فتحت تحقيقا بشأن تحويلات أجراها سلامة.
قال تيدروس أدهانوم غيبريسوس، المدير العام لمنظمة الصحة العالمية، أمس (الاثنين) إن العالم على شفا «فشل أخلاقي كارثي» فيما يتعلق بتوزيع لقاحات الوقاية من «كوفيد - 19».
بعد أن طغى الحديث في الأوساط العلمية خلال الأشهر الأخيرة من العام الذي انقضى عن تقنيّة الحمض النووي الريبي (RNA) المبتكرة التي تستخدم لإنتاج اللقاحات التي يعوّل عليها العالم في حربه الصحيّة والاقتصادية ضد جائحة «كوفيد - 19»، بات من شبه المؤكد أن تكون جائزة نوبل للطب هذه السنة من نصيب الباحثين الذين كان لهم الباع الأطول في تطوير هذا التقنية التي تفتح أيضاً أبواباً واسعة لتطوير علاجات ولقاحات ضد العديد من الأمراض المستعصية. لكن خلافاً للاعتقاد السائد بأن هذه التقنية هي وليدة الأبحاث المكثّفة والسريعة خلال الأشهر المنصرمة، تذكّر الأوساط العلمية بأن عشرات الباحثين ينشطون منذ نحو ثلاثة عقود لتطويره
تُعرف سويسرا بأنّها موطن الجبال، ولكن هل تعلم أنّ بها أكثر من 1500 بحيرة ومسطح مائي؟ تطل أغلب المدن السويسرية تقريباً على شواطئ بحيرات. وسواء كان ذلك بسبب الارتفاع أو المياه الصافية أو جمال المناظر المحيطة، هناك شيء استثنائي بشأن البحيرات المتلألئة في سويسرا، حسب موقع «ترافل ديلي». سنذكر لكم أجمل ثلاث بحيرات في سويسرا للراغب بزيارتها وهي، بحيرة جنيف أكبر بحيرة في وسط أوروبا وهي بحيرة عميقة على شكل هلال تطلّ على جبال الألب. ويمكن للزائر حجز رحلة بحرية أو رحلة طهوية للاستمتاع بالمشاهد الخلابة مثل شعار مدينة جنيف «جيتدو»، وهي نافورة يصل ارتفاع مياهها لـ140 متراً وتضاء في المساء.
أقفلت السنة «الموبوءة» على ١.٨ مليون حالة وفاة في العالم بسبب من جائحة كوفيد١٩، فيما كانت ٩ دول أوروبية على قائمة البلدان الخمسة عشر التي سجلت أكبر نسبة من الوفيات قياساً بعدد السكان.
لم تشترك بعد
انشئ حساباً خاصاً بك لتحصل على أخبار مخصصة لك ولتتمتع بخاصية حفظ المقالات وتتلقى نشراتنا البريدية المتنوعة